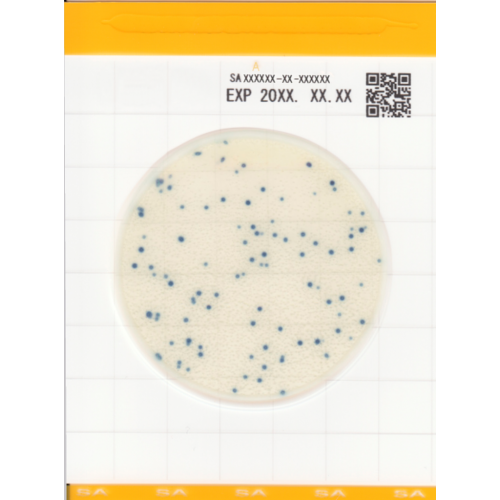
Easy Plate SA - Placi Teste Staphylococcus Aureus Rapide

Listeria Swabs - Kit Detectie Listeria monocytogenes
Transport Gratuit
Pentru comenzi peste 500 lei
Calitatea produselor garantata
Un nivel ridicat de calitate va determina o satisfacție mai deplină a clientului
Listeria Swabs - teste pentru Listeria monocytogenes ofera o metoda simpla si eficienta de identificare a contaminarii in industri alimentara.
Caracteristici Principale:
Detectie rapida si precisa - rezultate in maxim 48 ore la 37°C, permitand identificarea rapida a contaminarii cu Listeria spp., in special L. monocytogenes.
Schimbare distincta de culoare - mediul Esculin imbunatatit produce o schimbare vizibila de la maro deschis la negru/maro inchis, indicand prezenta Listeria.
Tampoane Calcium Alginate - varful tamponului se dizolva complet in mediu, asigurand contactul direct al tuturor microorganismelor cu mediul de cultura.
Test autonom complet - kit independent care nu necesita reagenti suplimentari, ideal pentru utilizarea in teren si laborator.
Viabilitate organismelor - permite testarea ulterioara a organismelor viabile in laboratoare specializate pentru confirmarea rezultatelor.
Specificatii tehnice:
- kit cu 25 de teste
- Timp incubatie: 48 ore la 37°C
- Durata de viata: 12 luni
- Depozitare: +5 la +25°C
- Lungime tampon: 15 cm
- Interpretare: maro deschis (negativ) / negru-maro inchis (pozitiv)
- Principiu: hidroliza esculinei de catre Listeria spp.
Listeria Swabs sunt utilizate pentru:
- Controlul calitatii in industria alimentara
- Testarea suprafetelor in bucatarii industriale
- Monitorizarea produselor lactate si de carne
- Detectia contaminarii in zone de procesare
- Controlul igienei in unitati de productie alimentara
- Testarea mediului de lucru pentru prevenirea contaminarii
- Usor de utilizat - procedura simpla, fara necesitatea de pregatire speciala
- Rezultate rapide - detectie in 48 ore comparativ cu metodele traditionale
- Siguranta ridicata - minimizeaza riscul de contaminare a zonei de lucru
- Precizie ridicata - mediul Esculin imbunatatit pentru detectia specifica
- Portabil - ideal pentru testarea in teren si controale la fata locului
Aceste tampoane Listeria reprezinta alegerea optima pentru laboratoarele si companiile din industria alimentara care necesita detectia rapida si sigura a Listeria monocytogenes, contribuind la prevenirea toxiinfectiilor alimentare si respectarea standardelor de siguranta HACCP.
Set de produse